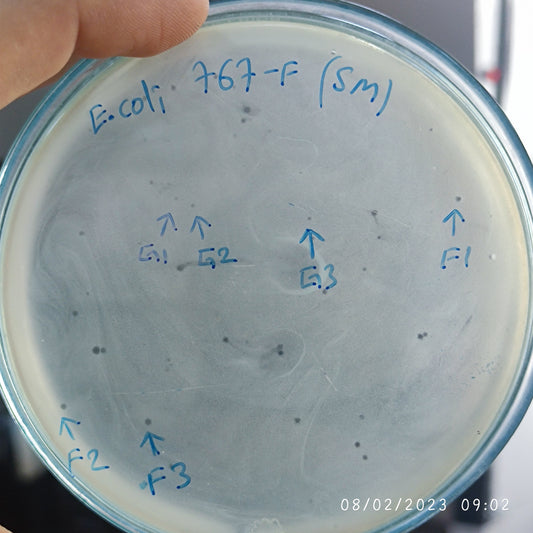
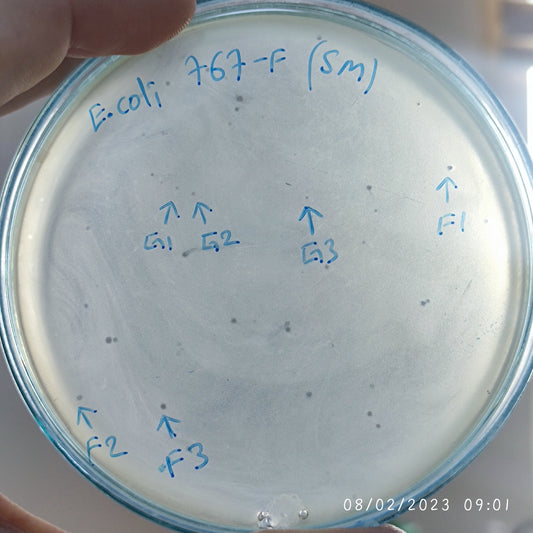
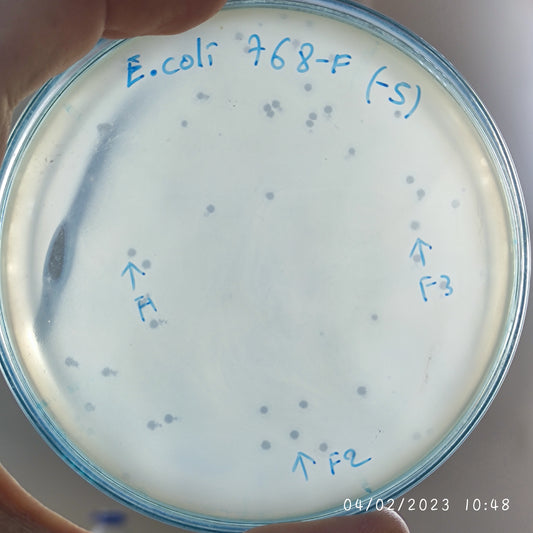
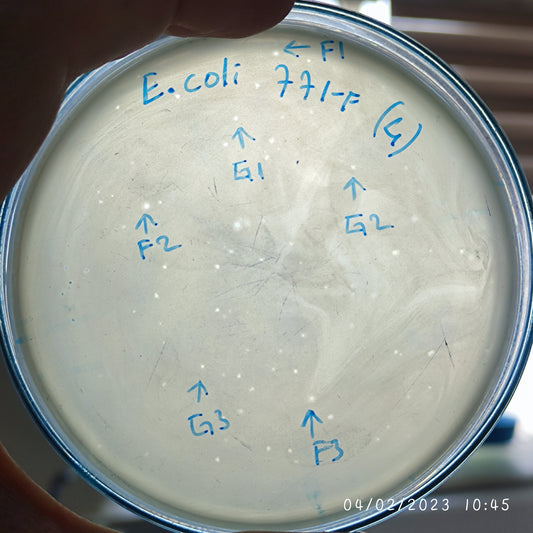
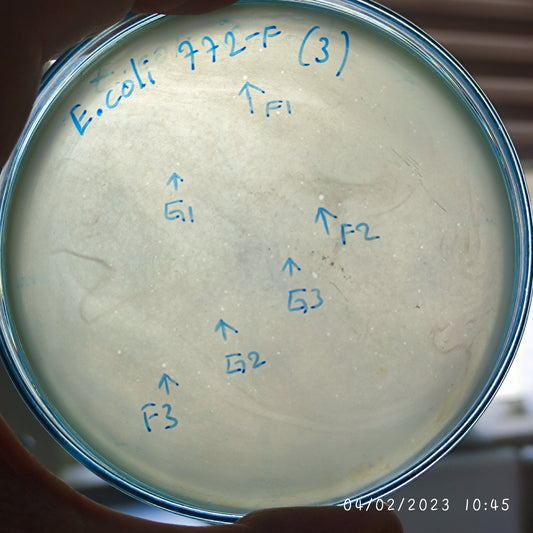
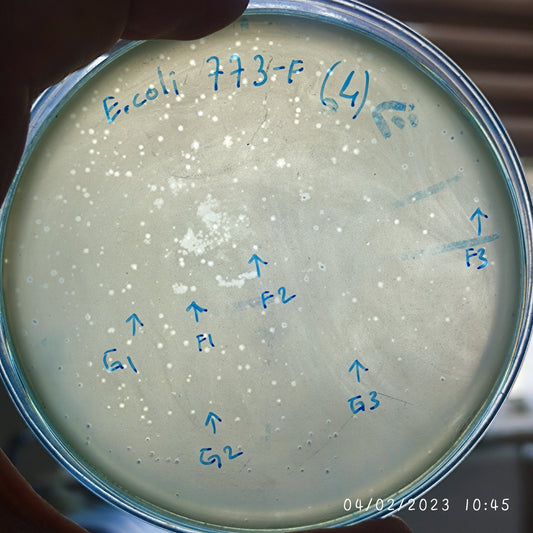
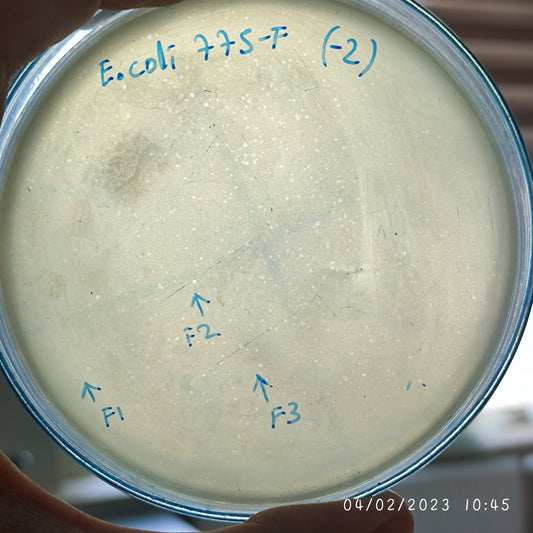
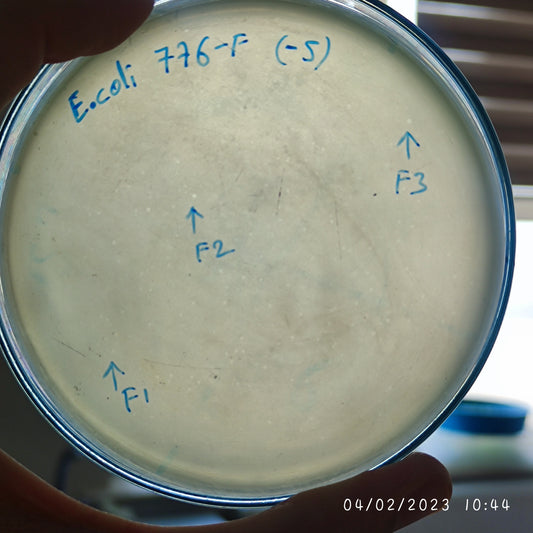
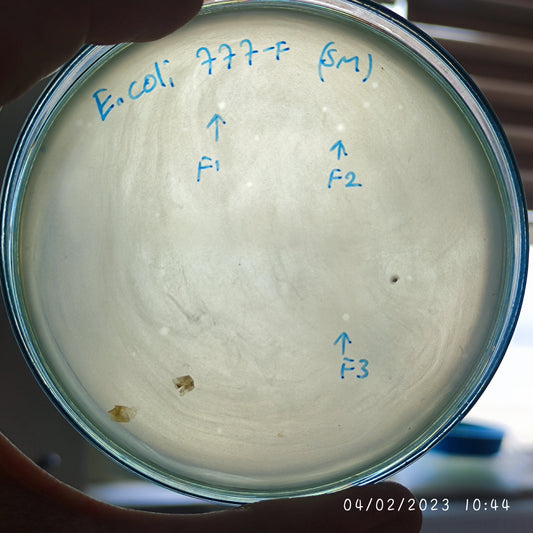
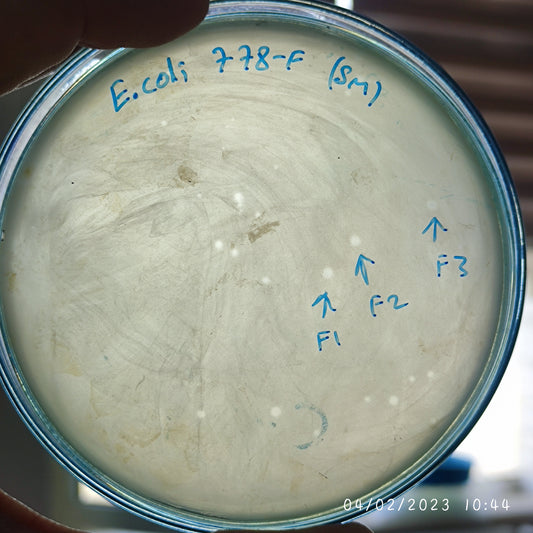
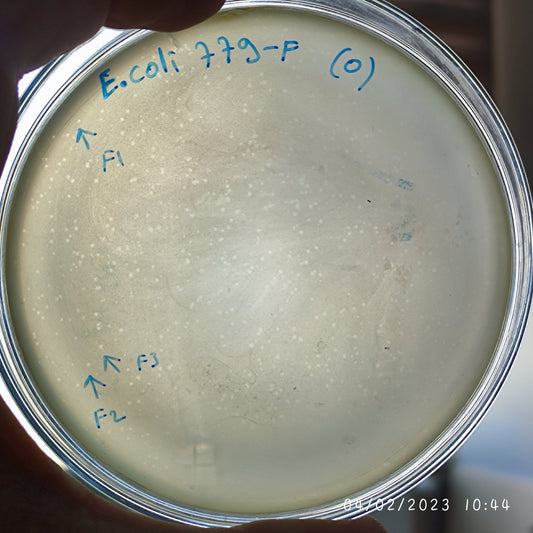

-
Escherichia coli bacteriophage 100767F
Regular price $750.00 USDRegular priceUnit price per -
Escherichia coli bacteriophage 100767G
Regular price $750.00 USDRegular priceUnit price per -
Escherichia coli bacteriophage 100768F
Regular price $750.00 USDRegular priceUnit price per -
Escherichia coli bacteriophage 100771F
Regular price $700.00 USDRegular priceUnit price per -
Escherichia coli bacteriophage 100771G
Regular price $750.00 USDRegular priceUnit price per -
Escherichia coli bacteriophage 100772F
Regular price $750.00 USDRegular priceUnit price per -
Escherichia coli bacteriophage 100772G
Regular price $750.00 USDRegular priceUnit price per -
Escherichia coli bacteriophage 100773F
Regular price $700.00 USDRegular priceUnit price per -
Escherichia coli bacteriophage 100773G
Regular price $750.00 USDRegular priceUnit price per -
Escherichia coli bacteriophage 100774F
Regular price $750.00 USDRegular priceUnit price per -
Escherichia coli bacteriophage 100775F
Regular price $750.00 USDRegular priceUnit price per -
Escherichia coli bacteriophage 100776F
Regular price $600.00 USDRegular priceUnit price per -
Escherichia coli bacteriophage 100777F
Regular price $750.00 USDRegular priceUnit price per -
Escherichia coli bacteriophage 100778F
Regular price $750.00 USDRegular priceUnit price per -
Escherichia coli bacteriophage 100779F
Regular price $650.00 USDRegular priceUnit price per -
Escherichia coli bacteriophage 100780F
Regular price $750.00 USDRegular priceUnit price per